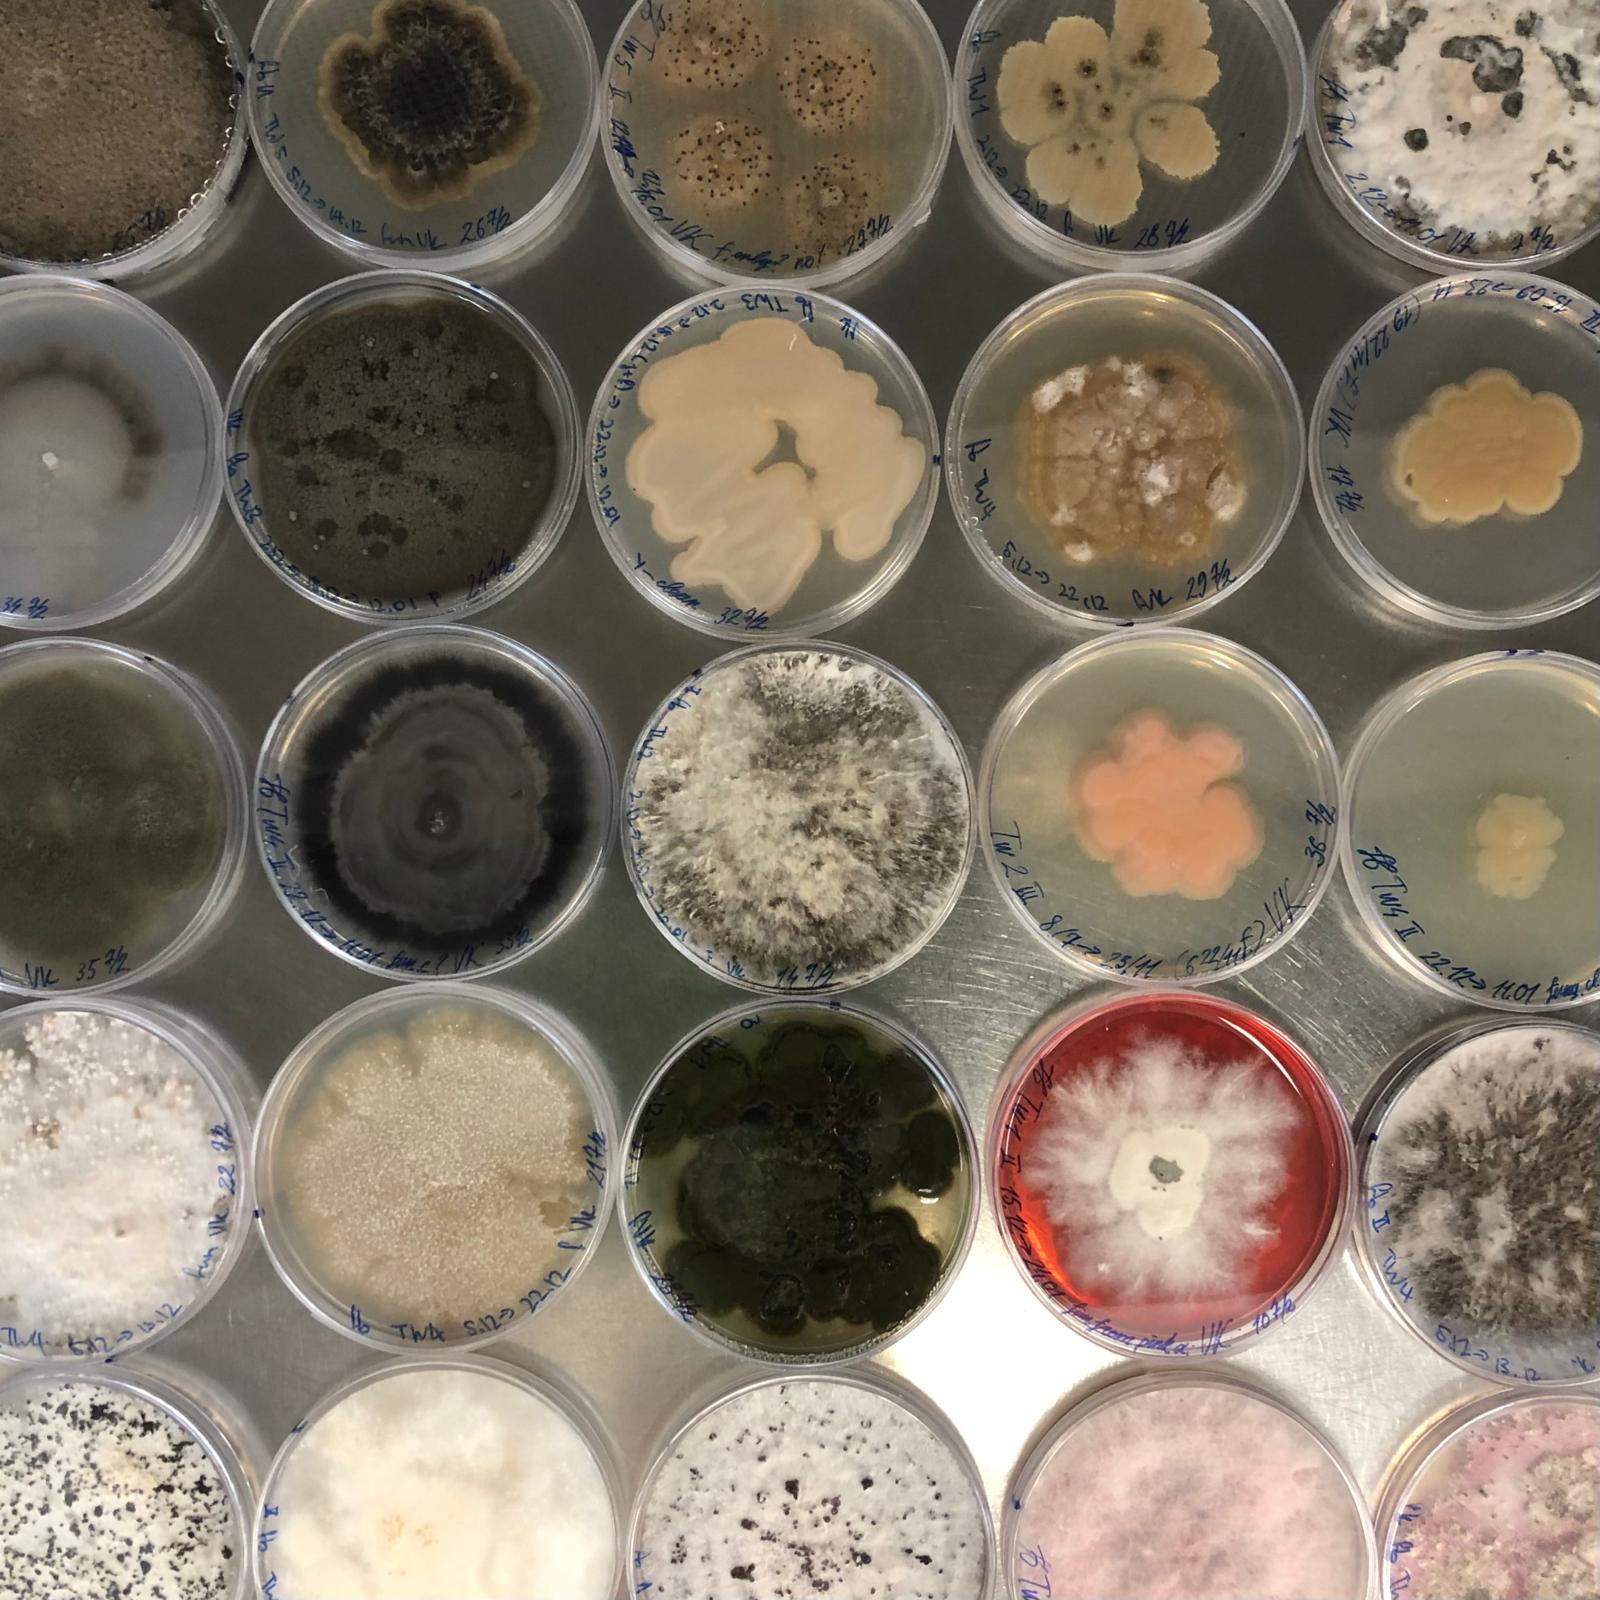
byondMyrtleRust's tweet card. Congratulations to our PhD student Vlad who has recently published a paper on the seed-borne microbiome of pōhutukawa in the New Zealand Journal of Botany! Jenny Leonard got to visit Vlad in the lab...

Beyond Myrtle Rust
@byondMyrtleRust
Beyond Myrtle Rust is a research programme that aims to study the behaviour, ecology, and impacts of the disease myrtle rust in New Zealand.
You might like
Register for our final webinar of the year! 🌿The molecular dialogue between Eucalyptus grandis and the myrtle rust pathogen 👩🔬Shae Swanepoel (University of Pretoria PhD candidate @Fabiteam1) 🕖 7:00pm NZST Wed. 13 November Abstract and registration 👉 bit.ly/3qWXc92
Myrtle rust impacts new growth. Since mature plants have both old and new growth, infection symptoms in large trees can be subtle at first. Here, we document the death of a pōhutukawa twig that succumbed to myrtle rust over the 2022/2023 summer.
🚨 Austropuccinia psidii (Myrtle rust) back on the EPPO Alert List eppo.int/ACTIVITIES/pla… Removed in 2003, it's now re-added due to its spread, expanded host range, and new aggressive strains. This aims to raise NPPO awareness on its risks in trade #PlantHealth


🌿🔎🟡 October @inaturalistnz report: Kicking off the season with 12 observations of myrtle rust during the month of October. As the weather warms, we expect to see more myrtle rust outbreaks on our native and garden myrtles, like this lillypilly hedge here.

Be sure to vote for Neomyrtus pedunculata! 🌿✅ The favourite plant vote closes this Sunday (3 Nov) bit.ly/4eXerPT
Our October webinar starts in 20 minutes! (11am NZST) Kristy Stevenson, a Research Associate at the @QUT, will share some early results from a project investigating forest community attributes and myrtle rust vulnerability. Register here 👉 attendee.gotowebinar.com/register/18336…
Join us tomorrow at 11am NZST for our October webinar! Kristy Stevenson, a Research Associate at the @QUT, will share some early results from a project investigating forest community attributes and myrtle rust vulnerability. Register here 👉 attendee.gotowebinar.com/register/18336…

For our October webinar, Kristy Stevenson, a Research Associate at the @QUT, will share some early results from a project investigating forest community attributes and myrtle rust vulnerability. Register here 👉 attendee.gotowebinar.com/register/18336…

Time to vote for your favourite plant! 💚🌿✅ Neomyrtus pedunculata, one of our most understudied myrtles, shares the common name "rōhutu" with a few other plants. We believe it deserves your support! Voting closes 3 November 👉 bit.ly/4eXerPT
Our PhD student Hoa has published a study on carbon fluxes at locations with different land-use histories and forest restoration strategies. This study contributes to understanding how resilient planted systems are to disturbances like myrtle rust. bit.ly/4gOqyjk
link.springer.com
Comparing forest carbon fluxes at locations with different land-use histories and restoration...
Plant and Soil - We compared carbon fluxes at locations differing in land-use history and forest restoration strategies, i.e., planted and naturally regenerating forests. We (1) quantified the...
Dynamite discovery for myrtle rust research! Our recent study on the molecular foundation of myrtle rust reveals how the pathogen breaks into a plant and how the plant responds. This insight will be useful for designing tools to prevent future break-ins. bit.ly/3YeD1FT
landcareresearch.co.nz
Dynamite discovery for myrtle rust research
A recent study looking at the molecular foundation of myrtle rust reveals how the pathogen breaks into a host plant and how the host plant responds. This insight will inform the design of useful...
Our monthly webinar series is back! 🌿🔎🟡 Join us Wednesday 18 September to learn more about 'E heke e Heka!' the myrtle rust learning app developed by @scion_research - You can register for the webinar here: attendee.gotowebinar.com/register/30215…

These trees aren't myrtles. But they are a good reminder that spring is on the way!🌸🌞 If you plan to prune your garden myrtles, like lilly pilly hedges, red dragon or pōhutukawa, please do so soon. Cold weather helps protect new growth from myrtle rust. 📷Magnolia and cherry


Great myrtle rust feature in @NZGeographic! We’re thrilled that award-winning science journalist @ellerykr chose to apply her skillful storytelling to a subject so close to our hearts. Wonderful to see Beyond Myrtle Rust voices in the mix. Article here: bit.ly/3Wh7Okq


If your lilly pilly hedge is due for a prune, please put it at the top of your to-do list. Pruning in winter should lead to healthier new growth. This in turn should keep myrtle rust spore numbers down, slowing the spread to our native plants. #PruneInJune landcareresearch.co.nz/discover-our-r…
landcareresearch.co.nz
Scientists advise pruning your lilly pilly hedges during winter to protect New Zealand’s native...
If you haven’t pruned your lilly pilly hedge recently, do so this winter. Research has shown that pruning in the winter can slow the spread of myrtle rust.
Join us TODAY 22 May at 11am NZST for our monthly webinar! bit.ly/3qWXc92 🧬Evidence for sexual reproduction in myrtle rust pathogen Austropuccinia psidii 🥼Presenter: Michael Bartlett, @scion_research
Join us tomorrow 22 May at 11am NZST for our monthly webinar! bit.ly/3qWXc92 🧬Evidence for sexual reproduction in myrtle rust pathogen Austropuccinia psidii 🥼Presenter: Michael Bartlett, @scion_research
Join us Wednesday 22 May at 11am NZST for our monthly webinar! bit.ly/3qWXc92 @scion_research

🔎🌿🟡 April @inaturalistnz report: 33 observations. There were 109 observations in April 2023. We look forward to digging into why this might be in our report of the summer season next month. For now, here’s what iNaturalist observations look like by year and by season.


Are you colourful and cultured? You may be a microbe! 🧫🦠 #MyrtaceaeMonday Our PhD student Vladislav Kholostiakov (@AucklandUni) has just published a paper (@royalsocietynz) on the culturable seed-borne microbiome of pōhutukawa. Congrats Vlad! bit.ly/3y8Qp3O
United States Trends
- 1. Josh Allen 31.6K posts
- 2. Texans 51.1K posts
- 3. Bills 145K posts
- 4. Joe Brady 4,740 posts
- 5. #MissUniverse 333K posts
- 6. #MissUniverse 333K posts
- 7. Anderson 25.9K posts
- 8. McDermott 4,015 posts
- 9. Maxey 10.5K posts
- 10. #TNFonPrime 3,047 posts
- 11. Al Michaels N/A
- 12. Costa de Marfil 21.4K posts
- 13. Dion Dawkins N/A
- 14. Shakir 5,456 posts
- 15. #htownmade 3,318 posts
- 16. CJ Stroud 1,147 posts
- 17. #BUFvsHOU 3,138 posts
- 18. James Cook 5,532 posts
- 19. Spencer Brown N/A
- 20. Knox 5,553 posts
Something went wrong.
Something went wrong.